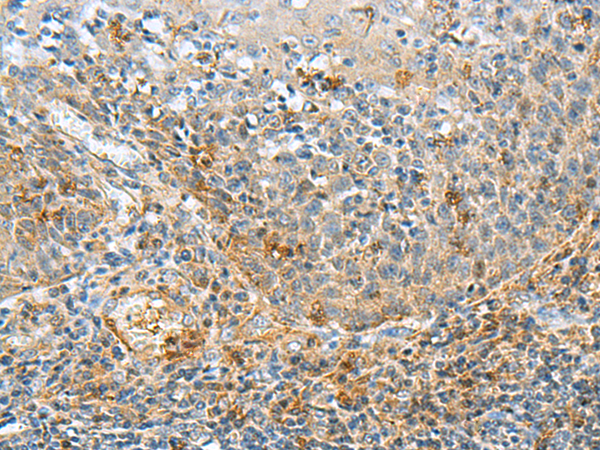

中文名稱:兔抗RMDN2多克隆抗體
英文名稱: Anti-RMDN2 rabbit polyclonal antibody
別 名: regulator of microtubule dynamics 2; RMD2; RMD4; RMD-2; FAM82A; BLOCK18; FAM82A1; PRO34163; PYST9371
相關(guān)類別: 一抗
儲 存: 冷凍(-20℃)
宿 主: Rabbit
抗 原: RMDN2
反應(yīng)種屬: Human, Mouse, Rat
標(biāo)記物: Unconjugate
克隆類型: rabbit polyclonal
Background:
The human protein FAM82A1, also known as regulator of microtubule dynamics 2 (RMD2), was one of three proteins identified as related to a family of microtubule-associated proteins in C. elegans. FAM82A1 contains multiple coiled-coil domains and localize to the spindle microtubules and spindle poles during cell division. During interphase, RMD2 localizes to the cytoplasm with protein observed in the microtubule lattice and perinuclear region.
Applications:
ELISA, IHC
Name of antibody:
RMDN2
Immunogen:
Fusion protein of human RMDN2
Full name:
regulator of microtubule dynamics 2
Synonyms:
RMD2; RMD4; RMD-2; FAM82A; BLOCK18; FAM82A1; PRO34163; PYST9371
SwissProt:
Q96LZ7
ELISA Recommended dilution:
5000-10000
IHC positive control:
Human cervical cancer and Human tonsil
IHC Recommend dilution:
50-300
技術(shù)規(guī)格

購物車
幫助
021-54845833/15800441009